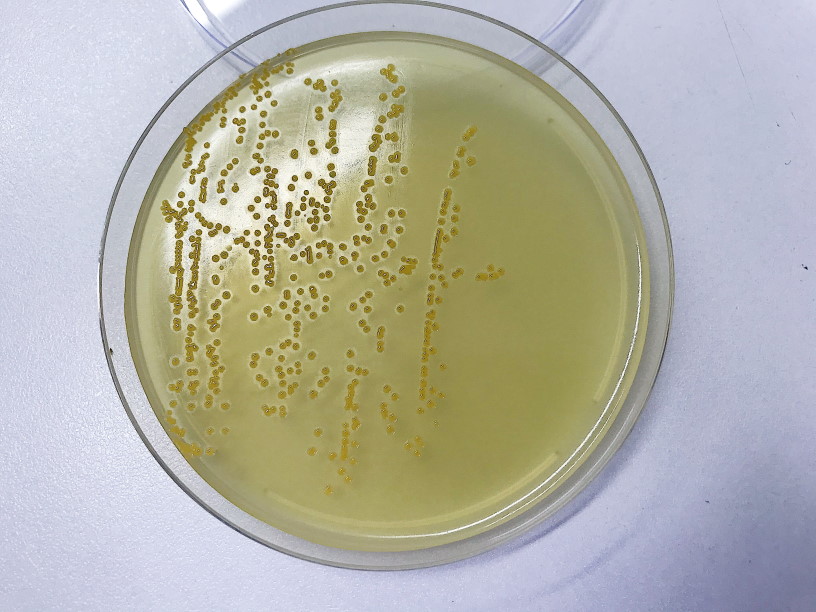

Екатерина Беленко: Промикробы: Опасный сосед
Золотистый стафилококк Фото: Екатерина Беленко Я люблю медицинские сериалы, ничего не могу с собой поделать. В одном из них была сюжетная ветка, связанная с внутрибольничным стафилококком — через некачественные пористые перчатки он пробирался в операционные раны, что было крайне плачевно для пациентов. Я уже рассказывала про стафилококк, но тогда больше затронула характеристики колоний и способы культивирования, а сейчас хочу поговорить об опасностях и болячках.
⠀
Патогенные стафилококки распространены повсеместно. Многие люди являются их носителями, например, в носовых проходах или на коже, даже сами об этом не догадываясь. Носителям стафилококки не причиняют вреда, но могут инфицировать и этого самого носителя, и других людей. Согласно некоторым источникам, обсемененность пациентов стационаров и медперсонала значительно выше среднего. Но нас, медицинских работников, проверяют очень тщательно и регулярно, так что не пугайтесь слишком сильно.
⠀
Стафилококки — грамположительные аэробные микроорганизмы, а золотистый стафилококк — самый известный и самый патогенный из всего семейства. Как правило, он вызывает инфекции кожи, может вызывать пневмонию, эндокардит и остеомиелит, привести к формированию абсцесса. Некоторые штаммы Staphylococcus aureus вырабатывают токсины, способные вызвать гастроэнтерит, синдром «ошпаренной кожи» и синдром токсического шока. Мощный микробик, да?
⠀
Лечить бактериальные инфекции надо антибиотиками, это очевидно, но с золотистым стафилококком не всё так просто. К некоторым эффективным против него антибиотикам стафилококк выработал устойчивость, что делает их применение абсолютно бессмысленным. Некоторые штаммы частично или полностью резистентны ко многим антибиотикам, кроме самых новых, к которым ещё просто не успели подобрать отмычки.
⠀
Людьми, предрасположенными к стафилококковой инфекции, являются:
• новорожденные младенцы и кормящие матери;
• пациенты с гриппом, хроническими бронхо-легочными заболеваниями (например, муковисцидоз, эмфизема), лейкемией, опухолями, хроническими кожными заболеваниями или сахарным диабетом;
• пациенты с трансплантатами, имплантированными протезами, другими инородными телами или имплантированными внутрисосудистыми пластмассовыми катетерами;
• пациенты, получающие глюкокортикоиды, иммуносупрессанты, лучевую терапию или противоопухолевую химиотерапию;
• инъекционные наркоманы;
• пациенты с хронической болезнью почек и находящиеся на диализе;
• пациенты с хирургическими разрезами, открытыми ранами или ожогами.
⠀
Закончить хочется банально. Берегите себя и своих близких: не применяйте антибиотики без консультации специалиста, а то потом не останется препаратов, способных убить злобного золотистого малыша.
Смотрите также: Екатерина Беленко Промикробы: Ода кишечной микрофлоре Екатерина Беленко Промикробы: Грибы большие и маленькие Екатерина Беленко Промикробы: моча, окутанная мифами Екатерина Беленко Промикробы: Загадочный дисбактериоз